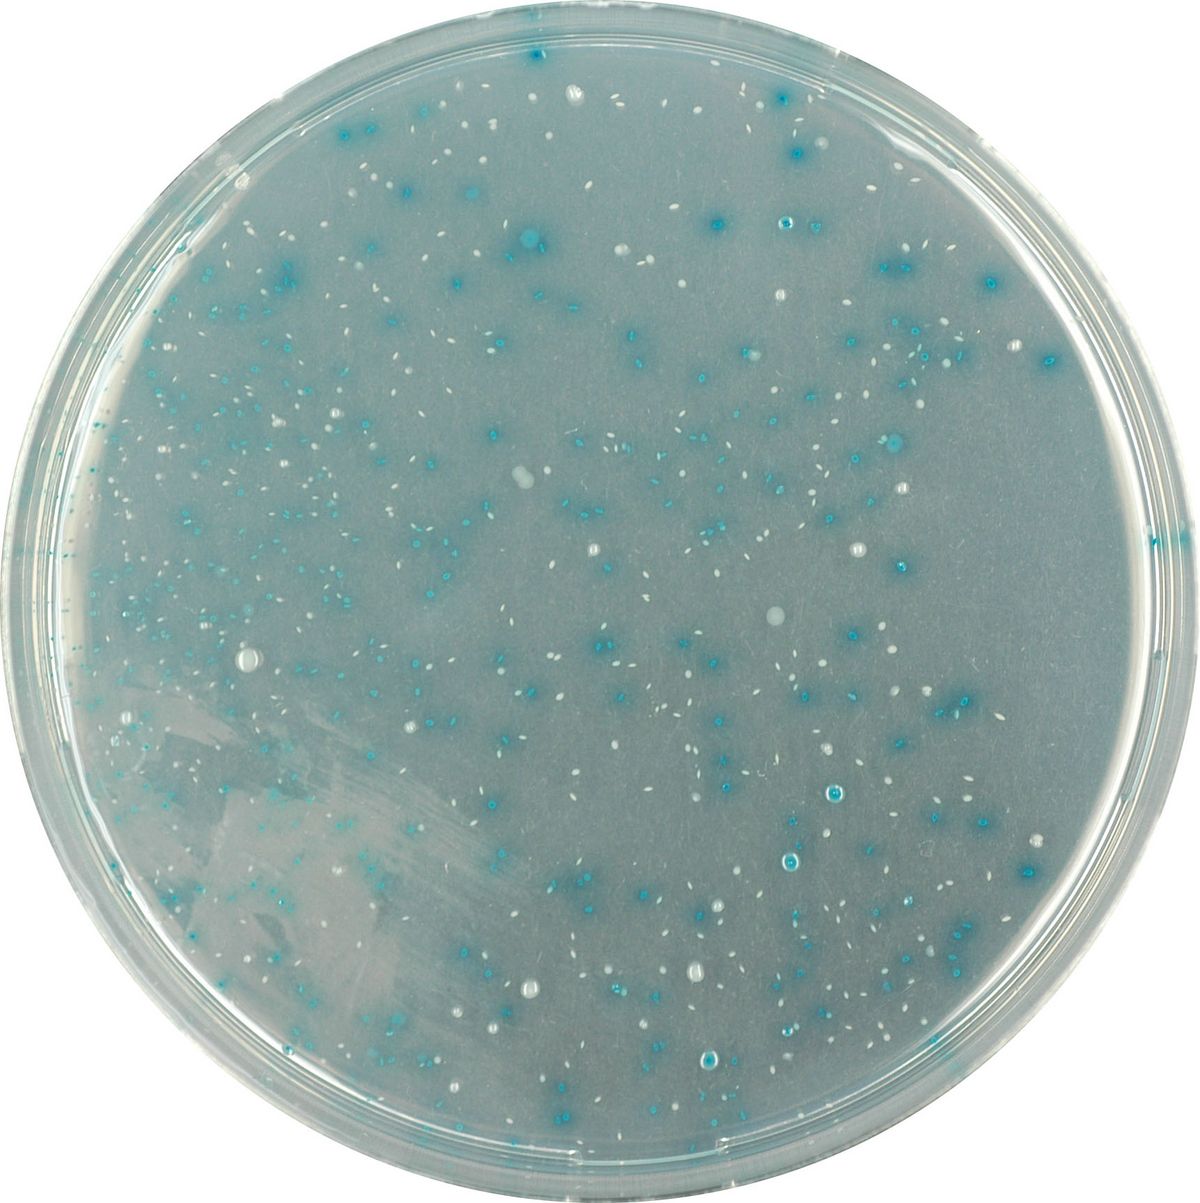
CHROMagar™ TBX - 500 g

EF343-500G
NB! New package size
Old package 5000 ml (EF342) dkk 2.250,00: 1 left in stock
For the simultaneous detection and enumeration of E. coli and other coliforms in water samples according to ISO9308-1 norm
Package size: 500 g
DKK 7.140,00
DKK 4.095,00
Not in stock, delivery 1-2 weeks
Chromogenic medium for the detection and enumeration of ß-glucuronidase positive E. coli in food and animal feeding stuffs according to NF EN ISO 16649 norm.
The product is composed of one single powder medium.
MEDIUM PERFORMANCE AND LIMITATIONS:
Sensitivity for E. coli is 96 % (Ogden et al. 1991)
Rare ß-glucuronidase negative E. coli strains are false negative on this medium (typically 0157 E. coli). If research is focused on rare pathogenic strains such as O157 E. coli : please refer to CHROMagar™ O157 product.
TYPICAL APPEARANCE OF MICROORGANISMS:
E. coli → blue
Othergram negative bacteria → colourles
Other gram positive bacteria → inhibited
The presence of E. coli indicates faecal contamination and potential presence of dangerous pathogens such as bacteria like Vibrio cholerae, Salmonella, Pseudomonas etc…, or viruses and intestinal parasites. The infections resulting from ingestion of contaminated matter can be dangerous and life-threatening.